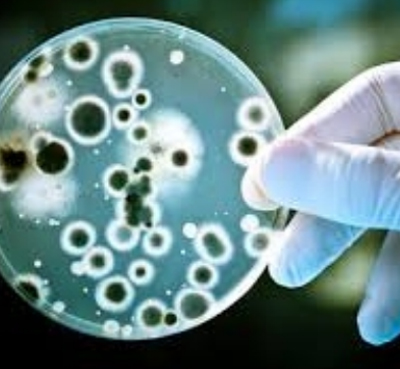

Pacer Analyzer, Electrical Safety, Analyzer, Electro surgery Analyzer, Endoscope Test Systems, Equipment Management Systems, Infusion Devise Analyzer, Oxygen Monitor, Paent Simulator Analyzer, Phototherapy Radiometer, Pressure Meter, Tachometer, Ultrasound Analyzer, Venlator/Gas Flow Analyzer, Portable Digital Dosimeter, Portable Personal Air Sampler, Connuous Radon-in-Air Monitor, Radiaon Survey Kit, Radiaon Teledetector Source, Gamma Probes